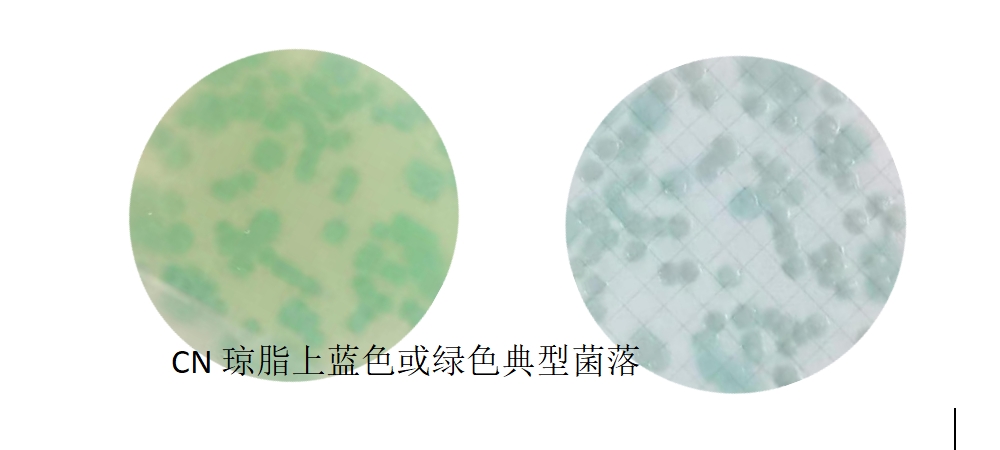
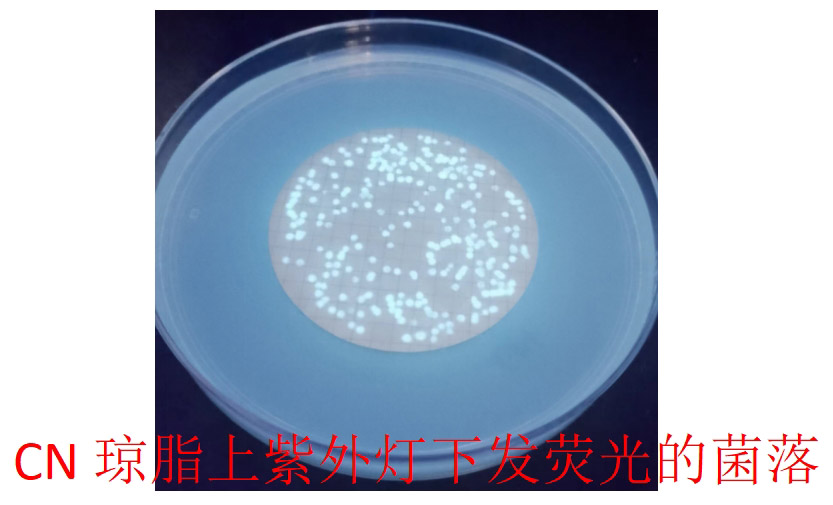

一起来聊聊水质铜绿假单胞菌检验那些事
发布时间:2025-05-09 浏览次数:5633
随着矿泉水标准GB8538-2022标准的实施,想必大家对铜绿假单胞菌的检验鉴定流程一定不再陌生,但每一项结果该如何判读?其原理和注意点有哪些呢,我们一起来盘点一下吧!
典型铜绿假单胞菌经薄膜过滤贴于CN琼脂上,长什么样子?以及确证实验该做哪些?一起来看看吧~
第一种情况:CN琼脂上蓝色或绿色的菌落,这典型特征可疑菌落,确证实验只需做绿脓菌素测定一项。
绿脓菌素试验的实验原理和关注点有哪些?一起来看看视频操作吧!
| 绿脓菌素测定结果图 | |||||
![]() | ![]() | ![]() | |||
| 阳性 | 阴性 | 阳性 | 阴性 | 阳性 | 阴性 |
| 培养后未加氯仿和盐酸 | 培养后加氯仿和盐酸 | 培养后只加盐酸 | |||
| (PS:绿脓菌素是水溶性色素,会发生可逆的氧化还原反应,氧化时碱性呈蓝色,酸性呈红色;在水中的溶解度比氯仿大,氯仿在此试验中只是起萃取作用,但氯仿属于第二类易制毒化学品,一般实验室不常备,因此,当测试菌产绿脓菌素,可直接加盐酸于测试管中,如培养基中的绿色变红色,也是产绿脓色素阳性反应。) | |||||
第二种情况:CN琼脂上非蓝色且非绿色菌落,紫外灯照射下发荧光。这典型特征可疑菌落,确证实验需做产氨试验和42℃生长测定两项。
产氨试验的实验原理和关注点有哪些?一起来看看视频操作吧!
42℃生长试验:即挑取菌苔在营养琼脂斜面上呈“之”字形划线,并于42±1℃进行培养,有菌苔生长,即为阳性,反之则为阴性。
第三种情况:CN琼脂上红褐的菌落,紫外灯照射下不发荧光,这典型特征可疑菌落,确证实验需做产氨试验、氧化酶试验、金氏B产荧光试验三项。
产氨试验同上,氧化酶试验的实验原理和关注点有哪些?一起来看看视频操作吧!
金氏B产荧光试验:用接种环蘸取待测纯培养物划线至金氏B琼脂斜面上,于36℃±1℃恒温箱培养1d~5d。每天需取出在紫外灯下检查其是否产生荧光,将5d内产生荧光的菌落记录为阳性。
![]() | ![]() | ||
| 阳性 | 阴性 | 阳性 | 阴性 |
| 产荧光试验(自然光下) | 产荧光试验(365nm紫外光下) | ||
| (PS:铜绿假单胞菌属于严格好氧菌,检验过程中每一步培养需注意半塞好氧培养!!) | |||
本次试验所用铜绿假单胞菌生化鉴定套盒为:
货号:071940;产品名称:铜绿假单胞菌生化鉴定盒(GB8538-2022)






